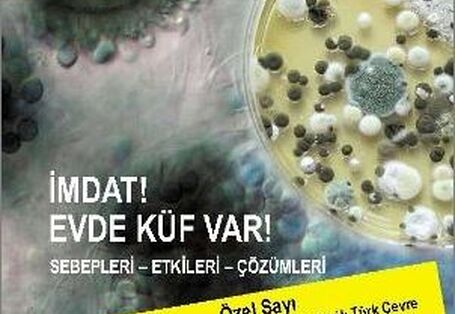

Bild vom
Publikation:Geoengineering - effective climate protection or megalomania?

… Publikation:Geoengineering - effective climate protection or megalomania? Quelle: … dieses Medium: Geoengineering - effective climate protection or megalomania? … Publikation:Geoengineering - effective climate protection or megalomania? …